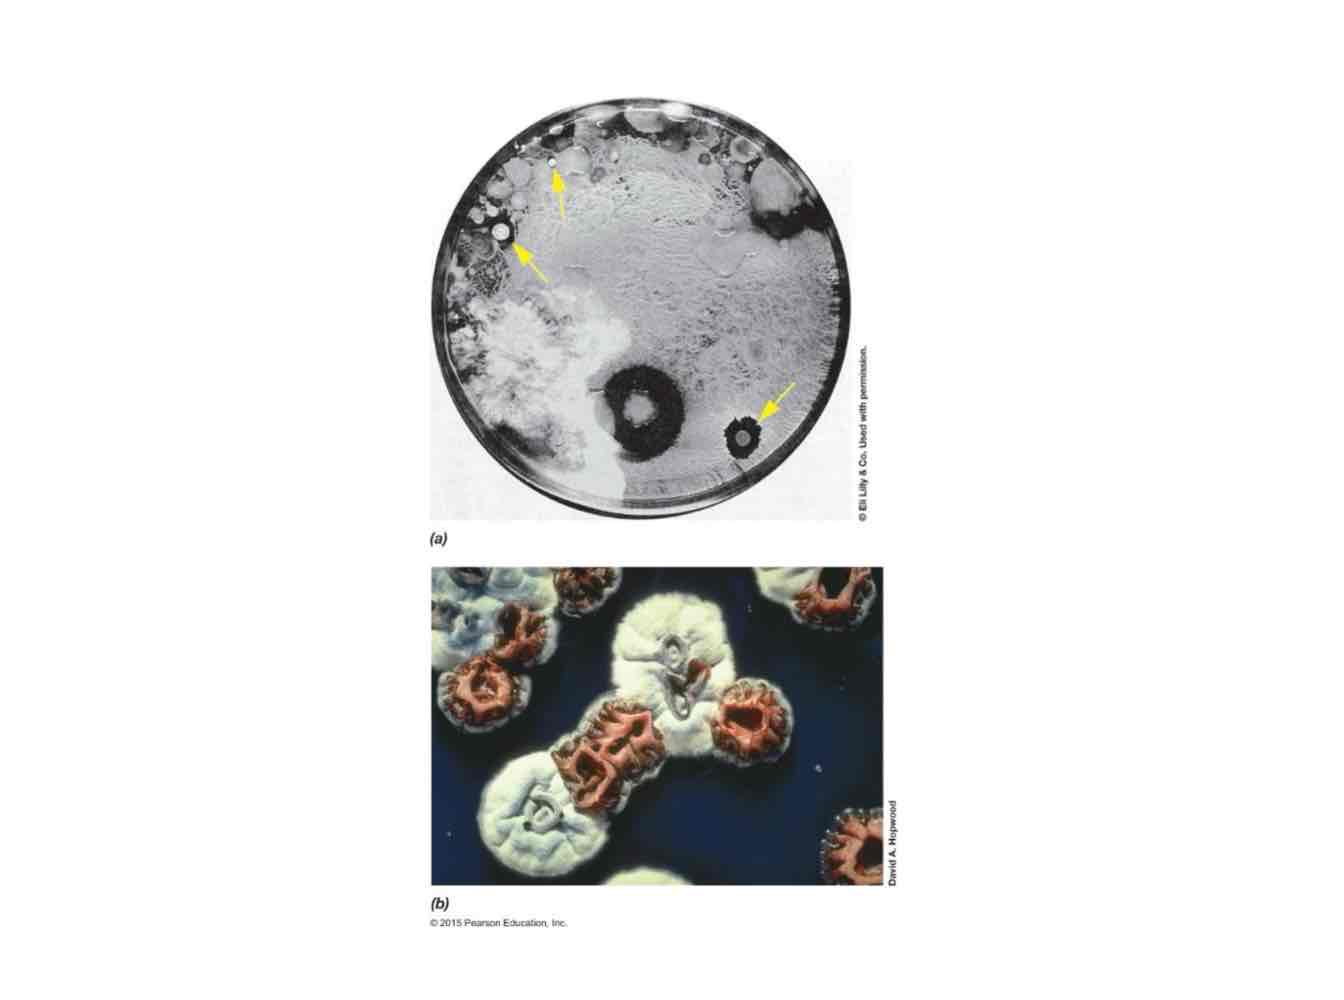
<p>Antibiotics.</p>

1/82
Looks like no tags are added yet.
Name | Mastery | Learn | Test | Matching | Spaced | Call with Kai |
|---|
No analytics yet
Send a link to your students to track their progress
What are the two ways to describe microbial diversity? Define how each groups microbed.
Phylogenetic diversity, wherein microbes are grouped into phyla based on evolutionary relationships.
Functional diversity, wherein microbes are grouped based on activities.
With what specific microbiological method is phylogenetic diversity usually figured out?
16S SSU rRNA gene sequencing.
With the functional diversity tree described in lecture, is the tree fully based on function? On that note, does one single function stay in one “branch” of the tree?
Some chunk of the tree starts off phylogenetically and ends functionally, with different functions spread out on different branches of the tree.

True or false: At the moment, most prokaryotes can be cultured in the lab. Briefly explain your aanswer.
False, they cannot. More phyla are known by their genome and not by their physical characters seen in vitro.

What does “type species” mean, in plain English? How about “sequenced species”?
Type species are species that can be grown to be known. Sequenced species are sequenced to be known.
What is metagenomics?
Study of a collection of different organisms' genomes within an environmental sample.
In the recent tree of life, what do the red dots mean?
Phyla only known from metagenome sequencing.

All we know is that they _____, not their _______ or what they are _____.
All we know is that they exist, not their function or what they are doing.
Newer trees will be more _______ and more _________.
Newer trees will be more branched and more complicated.
What are the ten phyla or major groups in Bacteria?
Proteobacteria.
Cyanobacteria.
Fermicutes.
Tenericutes.
Actinobacteria.
Bacteriodetes.
Chlamydiae.
Planctomycetes.
Hyperthermophilic bacteria.
Deinococcus-Thermus.

True or false: Proteobacteria includes many of the most commonly encountered bacteria.
True.
True or false: Proteobacteria is the most metabolically diverse phylum.
True.
Simply, what can Proteobacteria be considered as?
Typical Gram negatives.
What are the four specific classes of bacteria that you can encounter in Proteobacteria?
Chemolithotrophs.
Chemoorganotrophs.
Anoxygenic phototrophs.
Facultative organisms, for Proteobacteria, mean that…?
They can do switch between the three metabolic strategies—chemolithotrophy, chemoorganotrophy, and anoxygenic phototrophy.
What are the six classes of Proteobacteria?
Alpha-
Beta-
Gamma-
Delta-
Epsilon-
Zeta-
What are the three Proteobacteria classes that are well-studied with many important species?
Alpha-
Beta-
Gamma-
What are the two Proteobacteria classes that are smaller but with a broad range of phenotypes?
Delta-
Epsilon-
What is the one Proteobacteria class that has been barely studied and has only one known species?
Zetaproteobacteria.
True or false: You can predict disease with phylogenetics.
False.
For Alphaproteobacteria, what’s the one specific character they have?
Either pathogenic or non-pathogenic.
What is an example of a non-pathogen in Alphaproteobacteria? What is its special ability?
Rhizobium leguminosarum forms root nodules on legume plants, forming a symbiotic relationship, wherein bacterium fixes nitrogen into a bioavailable form and the plant provides nutrients and home for bacteria.

What is an example of a pathogen in Alphaproteobacteria? How is it transmitted? What illness does it cause?
Rickettsia ricketsii is transmitted by insect bites, causing the Rocky Mountain spotted fever.
For Betaproteobacteria, what are the two specific characters they have?
Either pathogenic or non-pathogenic.
Metabolically diverse.

What is an example of a non-pathogen in Betaproteobacteria? Where does it live?
Neisseria mucosa can be found on mucous membranes on tongues.
What is an example of a pathogen in Betaproteobacteria? What illness does it cause?
Neisseria gonorrhoeae causes STI gonorrhea.
For Gammaproteobacteria, what are the two specific characters they have?
Metabolically and ecologically diverse.
Many grow well in vitro and have become research models.

What is the member of Gammaproteobacteria that is well-known as an indicator of fecal contamination? Provide its:
Gram reaction.
Shape.
Class based on oxygen response.
Motility and flagella.
Fermentation.
Location.
Escherichia coli is described by:
Gram negative.
Rod-shaped.
Facultative anaerobe.
Motile with peritrichous flagella.
Ferments lactose to a mixture of acids, alcohols, and gases.
Large intestine of warm-blooded animals.
What is the member of Gammaproteobacteria that is naturally resistant to many antibiotics and disinfectants and is an opportunistic pathogen? Provide its:
Gram reaction.
Shape.
Motility and flagella.
Fermentation.
Pathogenic ability.
Pseudomonas aeruginosa is described by:
Gram-negative.
Rod-shaped.
Motile and polar flagella.
No sugar fermentation.
Opportunistic pathogen, causing respiratory tract infections in cystic fibrosis patients.

What does “opportunistic pathogen” mean?
Pathogens causing infections in immunocompromised patients.
For Deltaproteobacteria, what is the one specific character they have?
They contain many species with strange behaviour.
What is the Myxococcus member of Deltaproteobacteria that was discussed in lecture? What is its special ability in regards to (a) nutrition and (b) growth?
Myxococcus xanthus has the special ability to (a) release exoenzymes to lyse other bacteria for nutrients and (b) have cells that migrate together to form complex multicellular fruiting bodies with each cell differentiating into myxospores for dispersal.

What is the Bdellovibrio member of Deltaproteobacteria that was discussed in lecture? Provide its:
Shape.
Rate of motility.
Predation.
Method of predation.
Parasitism.
Bdellovibrio bacteriovorus is a curved, highly motile predator of other Proteobacteria and other Gram negative bacteria, penetrating the cell wall and multiplying in periplasm. They parasitically use macromolecules obtained directly from the host.
What do Gram negatives have that is so important in the periplasm for Bdellobirvio bacteriovorus?
Everything that it eats is in the periplasm.

For Epsilonproteobacteria, what are the two specific characters they have?
Small class.
Mostly famous for a few microaerophilic, spirillum-shaped pathogens.
What is the one member of Epsilonproteobacteria that was discussed in lecture? Where is it transmitted? What illness does it cause?
Campylobacter jejuni is frequently transmitted in under-cooked chicken and causes food-borne illnesses like gastroenteritis and bloody diarrhea.

For Cyanobacteria, what are the three specific characters they have?
Morphologically diverse, typically larger than other bacteria.
Can either be unicellular, filamentous, or branching filamentous.
Some form heterocysts.

What are heterocysts?
Nitrogen-fixing cells.
Answer these questions for me, on the note of Cyanobacteria
What metabolic process do they usually carry out? What does this process do?
What is their class based on carbon source?
Like chloroplast, what do they do?
Unlike chloroplasts, what do they have and contain instead?
Where can you find Cyanobacteria?
What are they known for, in regard to nutrition?
Carries out oxygenic photosynthesis, which is harvesting light and producing oxygen.
Autotroph.
They perform photosynthesis.
They have a Gram-negative cell wall type.
They are widely distributed in terrestrial, freshwater, and marine habitats.
They have the lowest nutritional requirement out of any organism because they get carbon & nitrogen from air and they can obtain their nutrients even in the smallest amounts in the environment.

What genus of Cyanobacteria is one of the most abundant organisms on Earth?
Prochlorococcus may account for half of photosynthesis in oceans or a third of photosynthesis on Earth.

Are all Cyanobacteria photosynthetic? Explain why or why not.
No, on and post-2020. There is a heterotrophic class within Cyanobacteria.

For Firmicutes, what are the four specific characters they have?
One of the two phyla with Gram positive cell walls.
Also known as the “low GC Gram positives.”
Includes lactic acid and non-lactic acid bacteria.
Includes endospore-forming bacteria.

What oxygen class of bacteria are lactic acid bacteria? What do they produce?
Aerotolerant anaerobes producing lactic acid as an end product of fermentation.
What are two examples of lactic acid bacteria from Firmicutes that were discussed in lecture? What are each known for?
Hint: One is known for human nutrition and the other is known for human destruction.
Lactobacillus delbrueckii is known for yogurt production via fermentation from milk.
Streptococcus pyogenes is known for the cause of strep throat, scarlet fever, and the flesh-eating disease.

What is one example of non-lactic acid bacteria from Firmicutes that was discussed in lecture? What is its oxygen class, osmolarity class, arrangement, location, and caused illness?
Staphylococcus aureus is a halotolerant, facultative anaerobe forming grape-like clusters, living on skin, frequently causing wound infections in surgery, i.e. nosocomial infections.

What genus consists of aerobic endospore formers? How about strictly anaerobic endospore formers?
Bacillus and Clostridium, respectively.

Where can you usually find endospore-formers?
Soil.
Most endospore-forming Firmicutes are non-pathogenic ________ soil organisms, but some can be dangerous ________.
Most endospore-forming Firmicutes are non-pathogenic saprophytic soil organisms, but some can be dangerous pathogens.
What does saprophytic mean?
Obtain nutrients by decomposing dead organic matter.
What is Bacillus subtilis used for studies?
Cell division and differentiation into endospores.

Where does Clostridium botulinum primarily live in? Where can you also find it? What specific enzymes does it secrete? What does its toxin cause?
Lives in tiny anoxic pockets within soil but also in anaerobic canned foods, secreting exoenzymes to degrade plant material and producing deadly botulism-causing neurotoxin.

What is botulism?
A quickly fatal disease.
What are the two proper canning procedures to destroy Clostridium botulinum?
Reach temp above 120ºC to destroy endospores.
Include sufficient acid or sugar to prevent endospore germination, as they aren’t halotolerant.
True or false: Only some Gram positives form endospores. Explain why or why not.
False. Only some Fermicutes form endospores, as there are also Gram negatives within Fermicutes that form endospores, called Negativicutes.
What does the existence of Negativicutes suggest, evolutionarily?
Suggest Gram positives were once Gram negatives that lost their OM and thickened peptidoglycan because of horizontal gene transfer.

What are Negativicutes closely related to?
Clostridium.
For Tenericutes, what are the two specific characters they have?
Phylogenetically related to gram positives, but they don’t have a cell wall, so they stain Gram negative.
Often pleomorphic.

What does pleomorphic mean?
No particular shape or misshaped.
What is the one member of Tenericutes that cause urethritis and pelvic inflammatory disease, transmitted through sex?
Mycoplasma genitalium.
What is Mycolplasma genitalium known for in regard ot genomics?
First free-living bacterium to have its genome sequenced because it has a small genome of 500 kbp.
For Actinobacteria, what are their four specific characteristics?
Second phylum of Gram positive bacteria.
Also known as the “high GC Gram positives.”
Includes coryneform bacteria or bacteria with “club-shaped” morphology.
Includes acid-fast and filamentous bacteria.
What Actinobacteria member that is deadly? What does it do to become deadly?
Corynebacterium diphtheriae produces an exotoxin inhibiting protein synthesis, causing tissue death in the respiratory tract, i.e. diphtheria, leading to death by suffocation

What well-known Actinobacteria informal grouping has a modified Gram positive cell wall? Describe its modification of the cell wall.
Mycobacteria has a layer of mycolic acids outside the peptidoglycan layer, making them acid-fast.

What does “acid-fast” mean?
Resistant to decolorization by acids during staining procedures.
How long do Mycobacterium tuberculosis colonies form on agar medium?
Weeks.
What genus mostly represents filamentous Actinobacteria? What special structures do they form? What does one of these special structures produce?
Streptomyces form branching hyphae and mycelia, with their hyphae producing spores for dispersal called conidia by a multiple fission event.

What energy class are majority of Streptomyces? Where do they specifically live in, and what do they give it to have an earthy smell?
Most are obligate aerobes, living in well aerated soils, giving soil its earthy smell via geosmins, i.e. metabolites produced by Streptomyces.
What substances do Streptomyces produce to kill or inhibit growth of other microbes?
Antibiotics.
What member of Streptomyces produce a famous antibiotic that was discussed in lecture? What’s the name of this antibiotic? What does this antibiotic do?
Streptomyces griseus produces streptomycin, which inhibits protein synthesis, active against Gram negative bacteria.
For Bacteroidetes, what are their three specific characteristics?
Also known as the “second largest typical gram negatives.”
Includes both aerobes and anaerbes.
Has few unifying characteristics.

What is a member of Bacteriodetes that was discussed in lecture? What is its oxygen class? Where can you find them? What enzymes does it produce, and what do these enzymes do?
Bacteroides thetaiotaomicron is a strict anaerobe found in the large intestine, producing polysaccharide-degrading enzymes, increasing variety of digestible plant polymers.
For Chlamydiae, what are their three specific characters?
Also known as the “less typical Gram negatives,” due to their peptidoglycan-lacking Gram negative cell wall.
Includes obligate intracellular parasites.
Has a life-cycle with two types of cells.
What are the two types of cells in the Chlamydiae life cycle? Which is metabolically active? Which is larger?
Elementary bodies are small & metabolically inactive, while reticulate bodies are large & metabolically active.
What does the elementary body’s special ability and its outcome? What does the reticulate body’s special ability and its outcome?
Elementary: Resists drying for some period of time, being able to go from host to host.
Reticulate: Multiply inside an existing host without infection.

What is the life cycle of Chlamydiae?
Elementary body attacks host cell.
Phagocytosis of elementary body.
Conversion into reticulate body.
Multiplication of reticulate bodies.
Conversion to elementary bodies.
Release of elementary bodies.

What is one member of Chlamydia that causes eye scars and blindness?
Chlamydia trachomatis.
For Planctomycetes, what are the four specific characters?
Gram negative but don’t have peptidoglycan.
Reproduce via the reproductive strategy budding, creating daughter cells.
Appendaged with a protein “stalk” used for attachment.
Some have membrane-bound compartments inside the cell.

As Planctomyces can have membrane-bound organelles, what membrane-bound organelle does Gemmata obscuriglobus have?
Nucleoid is surrounded by a true-unit membrane made of phospholipids.
There are several ______ branching phyla consisting of hyperthermophilic bacteria. These bacteria grow happily between ___ºC and ___ºC. All this suggest that ____ may have been a hyperthermophile.
There are several deeply branching phyla consisting of hyperthermophilic bacteria. These bacteria grow happily between 85ºC and 95ºC. All this suggest that LUCA may have been a hyperthermophile.

What are the two famous species in Deinococcus-Thermus?
Taq and Deinococcus radiodurans.
What is the temperature class and specific energy source, electron source, and carbon source class of Taq?
Thermophile and chemoorganoheterotroph.
What are two of Deinococcus radiodurans’ special abilities?
Extremely resistant to radiation and great DNA repair bacteria.

What arrangement is Deinococcus radiodurans usually in? How does this help repair DNA?
They form pairs or tetrads. If both cells are damaged, you can fuse nucleoids and mix-and-match pieces of the compact DNA to form a functioning chromosome to facilitate repair.